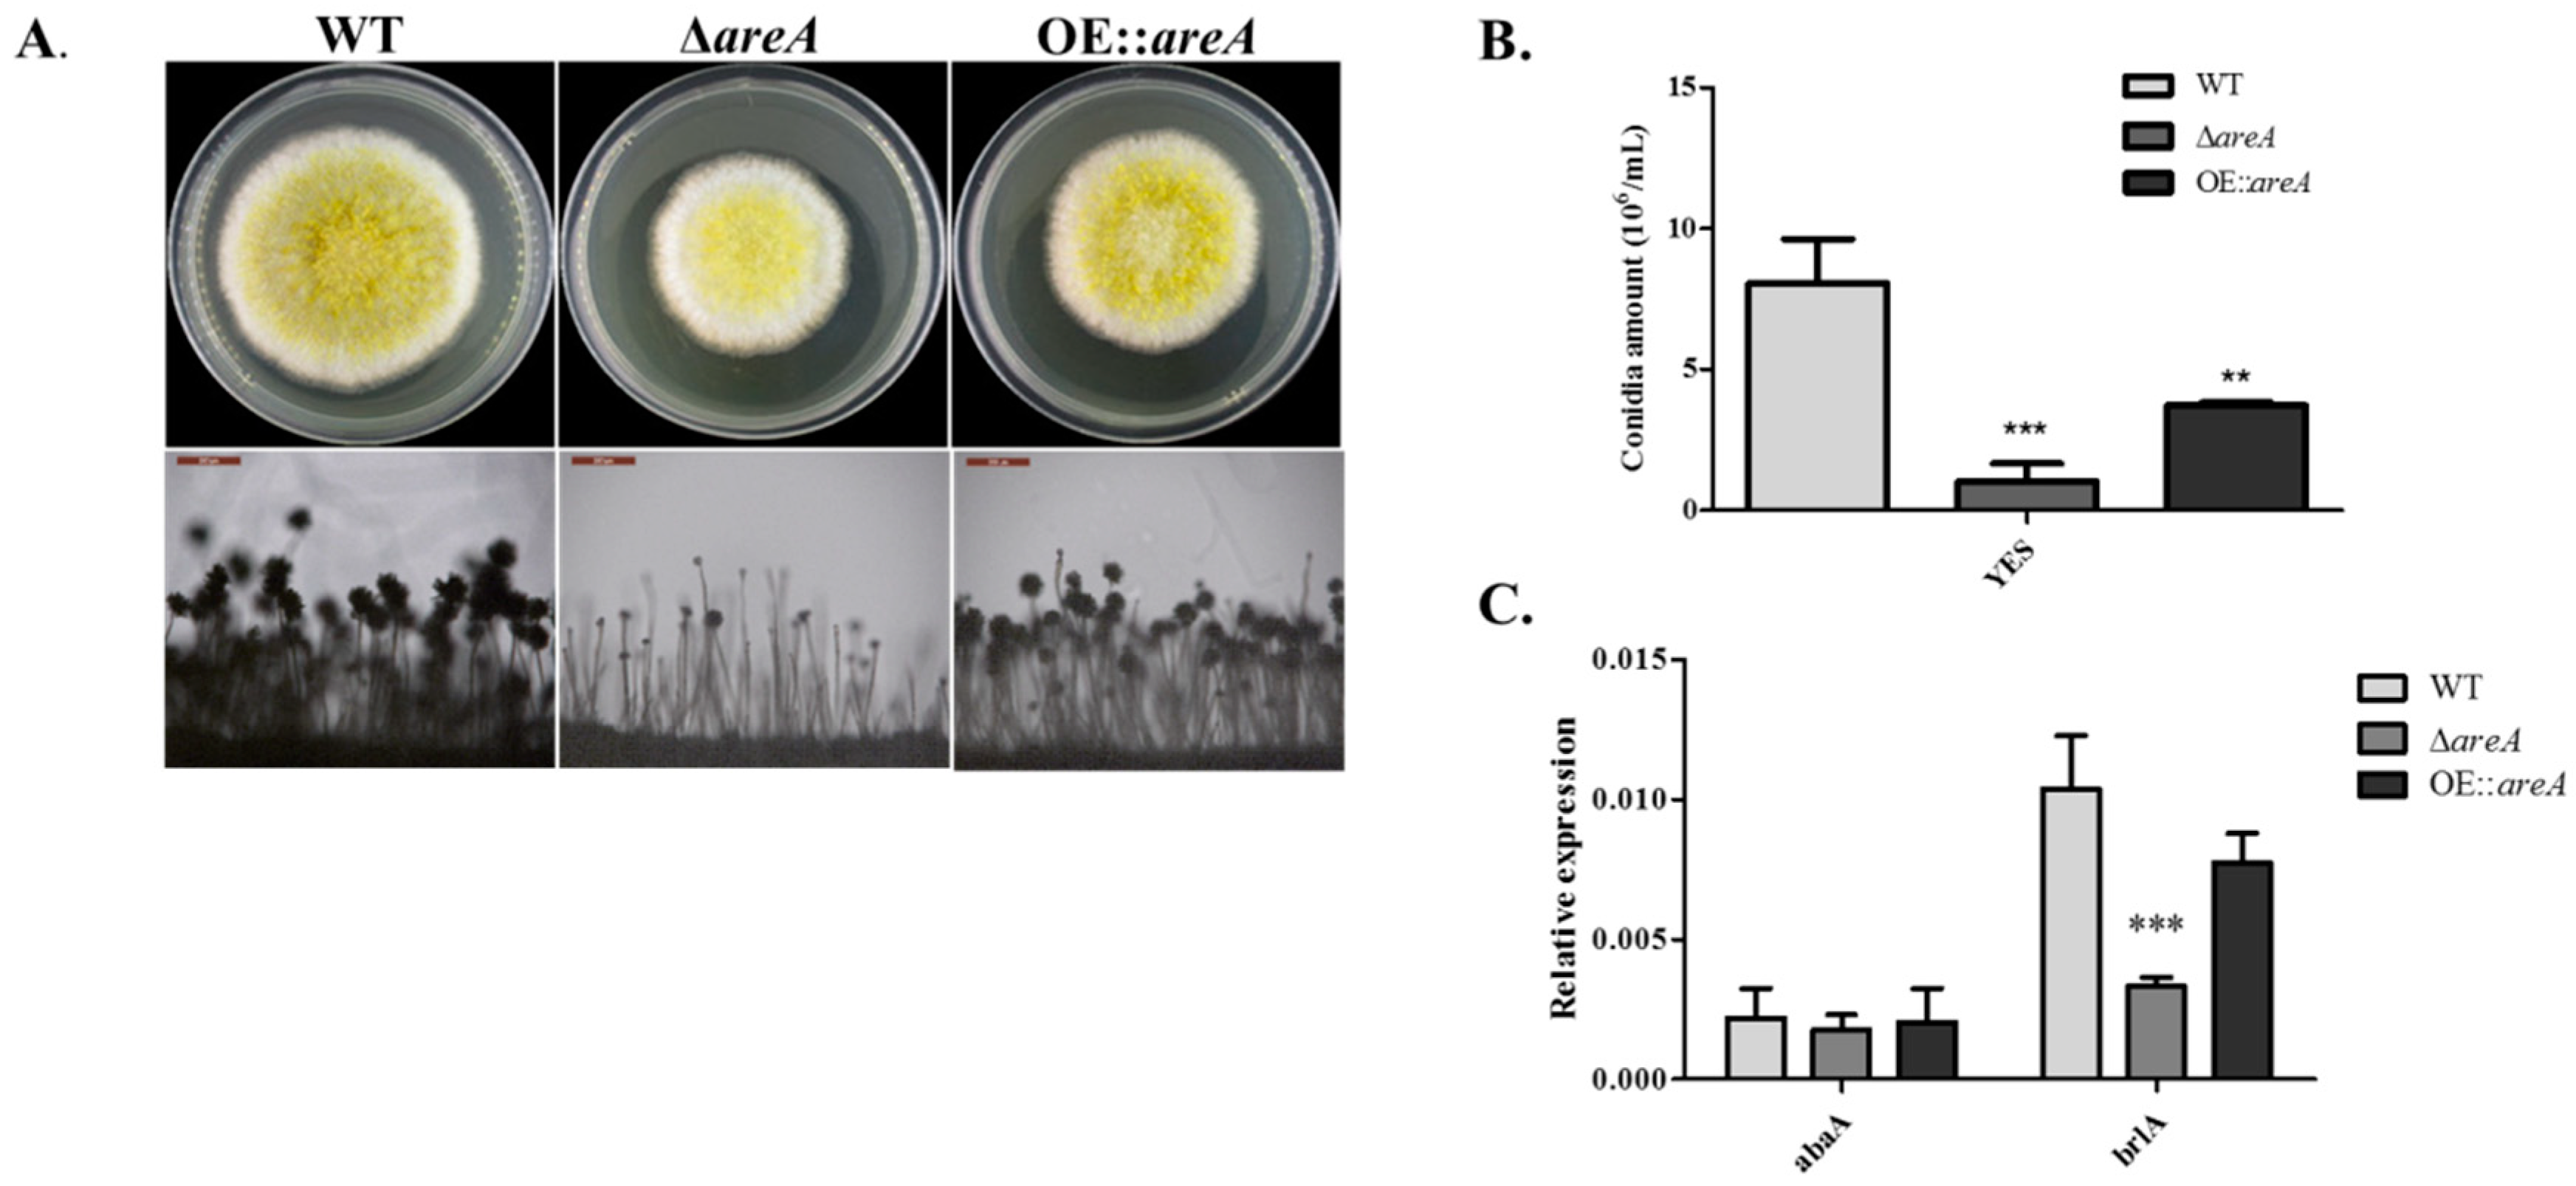
Toxins 11 00718 g004 Toxins 11 00718 g004

Regulation of Morphology, Aflatoxin Production, and Virulence of Aspergillus flavus by the Major Nitrogen Regulatory Gene areA
Abstract
1. Introduction
2. Results
2.1. Identification of AreA from A. flavus
2.2. Construction of areA Deletion (ΔareA) and Over-Expression (OE::areA) Mutant Strains
2.3. areA is Important for Nitrogen Utilization and Growth of A. flavus
2.4. areA Influences Conidia Production of A. flavus
2.5. areA Impedes Sclerotia Formation in A. flavus
2.6. areA Influences the Stress Responses of A. flavus
2.7. Aflatoxin Biosynthesis is Partially Regulated by AreA
2.8. areA is Necessary for the Pathogenicity of A. flavus
2.9. Subcellular Localization of AreA in A. flavus
3. Discussion
4. Materials and Methods
4.1. Strains and Culture Conditions
4.2. Bioinformatics Analysis of AreA Sequence
4.3. Targeted Deletion and Over-Expression of the A. flavus areA Gene
4.4. Growth, Conidia and Sclerotia Production Analysis
4.5. AF extraction and Analysis
4.6. Stress Assay
4.7. Pathogenicity Assay
4.8. Subcellular Localization
4.9. Quantitative Reverse Transcription Polymerase Chain Reaction
4.10. Statistical Analysis
Author Contributions
Funding
Acknowledgments
Conflicts of Interest
References
- Cotty, P.J. Virulence and Cultural Characteristics of Two Aspergillus flavus Strains Pathogenic on Cotton. Phytopathology 1989, 79, 808–814. [Google Scholar] [CrossRef]
- Michailides, T.; Thomidis, T. First report of Aspergillus flavus causing fruit rots of peaches in Greece. Plant Pathol. 2007, 56, 352. [Google Scholar] [CrossRef]
- Klich, M.A. Aspergillus flavus: The major producer of aflatoxin. Mol. Plant Pathol. 2007, 8, 713–722. [Google Scholar] [CrossRef] [PubMed]
- Geiser, D.M.; Timberlake, W.E.; Arnold, M.L. Loss of Meiosis in Aspergillus. Mol. Biol. Evol. 1996, 13, 809–817. [Google Scholar] [CrossRef]
- Yu, J. Current understanding on aflatoxin biosynthesis and future perspective in reducing aflatoxin contamination. Toxins 2012, 4, 1024–1057. [Google Scholar] [CrossRef]
- Amaike, S.; Keller, N.P. Aspergillus flavus. Annu. Rev. Phytopathol. 2011, 49, 107–133. [Google Scholar] [CrossRef]
- Bai, Y.; Lan, F.; Yang, W.; Zhang, F.; Yang, K.; Li, Z.; Gao, P.; Wang, S. sRNA profiling in Aspergillus flavus reveals differentially expressed miRNA-like RNAs response to water activity and temperature. Fungal Genet. Biol. 2015, 81, 113–119. [Google Scholar] [CrossRef]
- Zhang, F.; Guo, Z.; Zhong, H.; Wang, S.; Yang, W.; Liu, Y.; Wang, S. RNA-Seq-based transcriptome analysis of aflatoxigenic Aspergillus flavus in response to water activity. Toxins 2014, 6, 3187–3207. [Google Scholar] [CrossRef]
- Zhang, F.; Zhong, H.; Han, X.; Guo, Z.; Yang, W.; Liu, Y.; Yang, K.; Zhuang, Z.; Wang, S. Proteomic profile of Aspergillus flavus in response to water activity. Fungal Biol. 2015, 119, 114–124. [Google Scholar] [CrossRef]
- Agrios, G.N. Chapter eleven—Plant diseases caused by fungi. In Plant Pathology, 5th ed.; Agrios, G.N., Ed.; Academic Press: San Diego, CA, USA, 2005; pp. 385–614. [Google Scholar]
- Marzluf, G.A. Genetic regulation of nitrogen metabolism in the fungi. Microbiol. Mol. Biol. Rev. 1997, 61, 17–32. [Google Scholar]
- Wang, B.; Han, X.; Bai, Y.; Lin, Z.; Qiu, M.; Nie, X.; Wang, S.; Zhang, F.; Zhuang, Z.; Yuan, J.; et al. Effects of nitrogen metabolism on growth and aflatoxin biosynthesis in Aspergillus flavus. J. Hazard. Mater. 2017, 324, 691–700. [Google Scholar] [CrossRef] [PubMed]
- Macios, M.; Caddick, M.X.; Weglenski, P.; Scazzocchio, C.; Dzikowska, A. The GATA factors AREA and AREB together with the co-repressor NMRA, negatively regulate arginine catabolism in Aspergillus nidulans in response to nitrogen and carbon source. Fungal Genet. Biol. 2012, 49, 189–198. [Google Scholar] [CrossRef] [PubMed]
- Schonig, B.; Brown, D.W.; Oeser, B.; Tudzynski, B. Cross-species hybridization with Fusarium verticillioides microarrays reveals new insights into Fusarium fujikuroi nitrogen regulation and the role of AreA and NMR. Eukaryot. Cell 2008, 7, 1831–1846. [Google Scholar] [CrossRef] [PubMed]
- Haas, H.; Marzluf, G.A. NRE, the major nitrogen regulatory protein of Penicillium chrysogenum, binds specifically to elements in the intergenic promoter regions of nitrate assimilation and penicillin biosynthetic gene clusters. Curr. Genet. 1995, 28, 177–183. [Google Scholar] [CrossRef] [PubMed]
- Froeliger, E.H.; Carpenter, B.E.; Froeliger, E. NUT1, a major nitrogen regulatory gene in Magnaporthe grisea, is dispensable for pathogenicity. Mol. Gen. Genet. MGG 1996, 251, 647–656. [Google Scholar] [PubMed]
- Xiao, X.; Marzluf, G.A. Identification of the native NIT2 major nitrogen regulatory protein in nuclear extracts of Neurospora crassa. Genetica 1996, 97, 153–163. [Google Scholar] [CrossRef]
- Mihlan, M.; Homann, V.; Liu, T.W.; Tudzynski, B. AREA directly mediates nitrogen regulation of gibberellin biosynthesis in Gibberella fujikuroi, but its activity is not affected by NMR. Mol. Microbiol. 2003, 47, 975–991. [Google Scholar] [CrossRef]
- Ravagnani, A.; Gorfinkiel, L.; Langdon, T.; Diallinas, G.; Adjadj, E.; Demais, S.; Gorton, D.; Arst HN Jr Scazzocchio, C. Subtle hydrophobic interactions between the seventh residue of the zinc finger loop and the first base of an HGATAR sequence determine promoter-specific recognition by the Aspergillus nidulans GATA factor AreA. EMBO J. 1997, 16, 3974–3986. [Google Scholar] [CrossRef]
- Xiao, X.; Fu, Y.H.; Marzluf, G. The Negative-Acting NMR Regulatory Protein of Neurospora crassa Binds to and Inhibits the DNA-Binding Activity of the Positive-Acting Nitrogen Regulatory Protein NIT2. Biochemistry 1995, 34, 8861–8868. [Google Scholar] [CrossRef]
- Platt, A.; Langdon, T.; Arst HNJr Kirk, D.; Tollervey, D.; Sanchez, J.M.; Caddick, M.X. Nitrogen metabolite signalling involves the C-terminus and the GATA domain of the Aspergillus transcription factor AREA and the 3’ untranslated region of its mRNA. EMBO J. 1996, 15, 2791–2801. [Google Scholar] [CrossRef]
- Andrianopoulos, A.; Kourambas, S.; Sharp, J.A.; Davis, M.A.; Hynes, M.J. Characterization of the Aspergillus nidulans nmrA gene involved in nitrogen metabolite repression. J. Bacteriol. 1998, 180, 1973–1977. [Google Scholar] [PubMed]
- Han, X.; Qiu, M.; Wang, B.; Yin, W.B.; Nie, X.; Qin, Q.; Ren, S.; Yang, K.; Zhang, F.; Zhuang, Z.; et al. Functional Analysis of the Nitrogen Metabolite Repression Regulator Gene nmrA in Aspergillus flavus. Front. Microbiol. 2016, 7, 1794. [Google Scholar] [CrossRef] [PubMed]
- Lopez-Berges, M.S.; Schäfer, K.; Hera, C.; Di Pietro, A. Combinatorial function of velvet and AreA in transcriptional regulation of nitrate utilization and secondary metabolism. Fungal Genet. Biol. 2014, 62, 78–84. [Google Scholar] [CrossRef] [PubMed]
- Crespo, J.L.; Hall, M.N. Elucidating TOR signaling and rapamycin action: Lessons from Saccharomyces cerevisiae. Microbiol. Mol. Biol. Rev. 2002, 66, 579–591. [Google Scholar] [CrossRef] [PubMed]
- Hunter, C.C.; Siebert, K.S.; Downes, D.J.; Wong, K.H.; Kreutzberger, S.D.; Fraser, J.A.; Clarke, D.F.; Hynes, M.J.; Davis, M.A.; Todd, R.B. Multiple nuclear localization signals mediate nuclear localization of the GATA transcription factor AreA. Eukaryot. Cell 2014, 13, 527–538. [Google Scholar] [CrossRef]
- Todd, R.B.; Fraser, J.A.; Wong, K.H.; Davis, M.A.; Hynes, M.J. Nuclear accumulation of the GATA factor AreA in response to complete nitrogen starvation by regulation of nuclear export. Eukaryot. Cell 2005, 4, 1646–1653. [Google Scholar] [CrossRef]
- Li, J.; Pan, Y.; Liu, G. Disruption of the nitrogen regulatory gene AcareA in Acremonium chrysogenum leads to reduction of cephalosporin production and repression of nitrogen metabolism. Fungal Genet. Biol. 2013, 61, 69–79. [Google Scholar] [CrossRef]
- Hou, R.; Jiang, C.; Zheng, Q.; Wang, C.; Xu, J.R. The AreA transcription factor mediates the regulation of deoxynivalenol (DON) synthesis by ammonium and cyclic adenosine monophosphate (cAMP) signalling in Fusarium graminearum. Mol. Plant Pathol. 2015, 16, 987–999. [Google Scholar] [CrossRef]
- Haas, H.; Bauer, B.; Redl, B.; Stöffler, G.; Marzluf, G.A. Molecular cloning and analysis of nre, the major nitrogen regulatory gene of Penicillium chrysogenum. Curr. Genet. 1995, 27, 150–158. [Google Scholar] [CrossRef]
- Kim, H.; Woloshuk, C.P. Role of AREA, a regulator of nitrogen metabolism, during colonization of maize kernels and fumonisin biosynthesis in Fusarium verticillioides. Fungal Genet. Biol. 2008, 45, 947–953. [Google Scholar] [CrossRef]
- Michielse, C.B.; Pfannmüller, A.; Macios, M.; Rengers, P.; Dzikowska, A.; Tudzynski, B. The interplay between the GATA transcription factors AreA, the global nitrogen regulator and AreB in Fusarium fujikuroi. Mol. Microbiol. 2014, 91, 472–493. [Google Scholar] [CrossRef] [PubMed]
- Tudzynski, B.; Homann, V.; Feng, B.; Marzluf, G.A. Isolation, characterization and disruption of the areA nitrogen regulatory gene of Gibberella fujikuroi. Mol. Gen. Genet. MGG 1999, 261, 106–114. [Google Scholar] [PubMed]
- Bi, F.; Ment, D.; Luria, N.; Meng, X.; Prusky, D. Mutation of AREA affects growth, sporulation, nitrogen regulation, and pathogenicity in Colletotrichum gloeosporioides. Fungal Genet. Biol. 2017, 99, 29–39. [Google Scholar] [CrossRef] [PubMed]
- Giese, H.; Sondergaard, T.E.; Sorensen, J.L. The AreA transcription factor in Fusarium graminearum regulates the use of some nonpreferred nitrogen sources and secondary metabolite production. Fungal Biol. 2013, 117, 814–821. [Google Scholar] [CrossRef] [PubMed]
- Arst, H.N.; Cove, D.J. Nitrogen metabolite repression in Aspergillus nidulans. Mol. Gen. Genet. MGG 1973, 126, 111–141. [Google Scholar] [CrossRef] [PubMed]
- Christensen, T.; Hynes, M.J.; Davis, M.A. Role of the Regulatory Gene areA of Aspergillus oryzae in Nitrogen Metabolism. Appl. Environ. Microbiol. 1998, 64, 3232–3237. [Google Scholar]
- Park, H.-S.; Yu, J.-H. Genetic control of asexual sporulation in filamentous fungi. Curr. Opin. Microbiol. 2012, 15, 669–677. [Google Scholar] [CrossRef]
- Min, K.; Shin, Y.; Son, H.; Lee, J.; Kim, J.C.; Choi, G.J.; Lee, Y.W. Functional analyses of the nitrogen regulatory gene areA in Gibberella zeae. FEMS Microbiol. Lett. 2012, 334, 66–73. [Google Scholar] [CrossRef]
- Tudzynski, B. Nitrogen regulation of fungal secondary metabolism in fungi. Front. Microbiol. 2014, 5, 656. [Google Scholar] [CrossRef]
- Brakhage, A.A. Regulation of fungal secondary metabolism. Nat. Rev. Microbiol. 2012, 11, 21. [Google Scholar] [CrossRef]
- Fox, E.M.; Howlett, B.J. Secondary metabolism: Regulation and role in fungal biology. Curr. Opin. Microbiol. 2008, 11, 481–487. [Google Scholar] [CrossRef] [PubMed]
- Ehrlich, K.C.; Chang, P.-K.; Yu, J.; Cary, J.W.; Bhatnagar, D. Control of Aflatoxin Biosynthesis in Aspergilli. In Aflatoxins-Biochemistry and Molecular Biology; IntechOpen: London, UK, 2011; pp. 21–40. [Google Scholar]
- Cary, J.W.; Ehrlich, K.C.; Kale, S.P.; Calvo, A.M.; Bhatnagar, D.; Cleveland, T.E. Regulatory elements in aflatoxin biosynthesis. Mycotoxin Res. 2006, 22, 105. [Google Scholar] [CrossRef] [PubMed]
- Liu, B.-H.; Chu, F.S. Regulation of aflR and Its Product, AflR, Associated with Aflatoxin Biosynthesis. Appl. Environ. Microbiol. 1998, 64, 3718–3723. [Google Scholar] [PubMed]
- Fasoyin, O.E.; Wang, B.; Qiu, M.; Han, X.; Chung, K.R.; Wang, S. Carbon catabolite repression gene creA regulates morphology, aflatoxin biosynthesis and virulence in Aspergillus flavus. Fungal Genet. Biol. 2018, 115, 41–51. [Google Scholar] [CrossRef] [PubMed]
- Gonzalez, R.; Gavrias, V.; Gomez, D.; Scazzocchio, C.; Cubero, B. The integration of nitrogen and carbon catabolite repression in Aspergillus nidulans requires the GATA factor AreA and an additional positive-acting element, ADA. EMBO J. 1997, 16, 2937–2944. [Google Scholar] [CrossRef] [PubMed]
- Duran, R.; Cary, J.W.; Calvo, A.M. Role of the osmotic stress regulatory pathway in morphogenesis and secondary metabolism in filamentous fungi. Toxins 2010, 2, 367–381. [Google Scholar] [CrossRef]
- Mellersh, D.G.; Foulds, I.V.; Higgins, V.J.; Heath, M.C. H2O2 plays different roles in determining penetration failure in three diverse plant–fungal interactions. Plant J. 2002, 29, 257–268. [Google Scholar] [CrossRef]
- Shetty, N.P.; Mehrabi, R.; Lütken, H.; Haldrup, A.; Kema, G.H.; Collinge, D.B.; Jørgensen, H.J. Role of hydrogen peroxide during the interaction between the hemibiotrophic fungal pathogen Septoria tritici and wheat. New Phytol. 2007, 174, 637–647. [Google Scholar] [CrossRef]
- Veal, E.A.; Day, A.M.; Morgan, B.A. Hydrogen Peroxide Sensing and Signaling. Mol. Cell 2007, 26, 1–14. [Google Scholar] [CrossRef]
- Lamb, C.; Dixon, R.A. The Oxidative Burst in Plant Disease Resistance. Annu. Rev. Plant Physiol. 1997, 48, 251–275. [Google Scholar] [CrossRef]
- Wojtaszek, P. Oxidative burst: An early plant response to pathogen infection. Biochem. J. 1997, 322 Pt 3, 681–692. [Google Scholar] [CrossRef]
- Snoeijers, S.S.; Pérez-García, A.; Joosten, M.H.A.J.; De Wit, P.J.G.M. The Effect of Nitrogen on Disease Development and Gene Expression in Bacterial and Fungal Plant Pathogens. Eur. J. Plant Pathol. 2000, 106, 493–506. [Google Scholar] [CrossRef]
- Proctor, R.H.; Hohn, T.M.; McCormick, S.P. Reduced virulence of Gibberella zeae caused by disruption of a trichothecene toxin biosynthetic gene. Mol. Plant-Microbe Interact. 1995, 8, 593–601. [Google Scholar]
- An, Z.; Mei, B.; Yuan, W.M.; Leong, S.A. The distal GATA sequences of the sid1 promoter of Ustilago maydis mediate iron repression of siderophore production and interact directly with Urbs1, a GATA family transcription factor. EMBO J. 1997, 16, 1742–1750. [Google Scholar] [CrossRef] [PubMed]
- Whiteside, S.T.; Goodbourn, S. Signal transduction and nuclear targeting: Regulation of transcription factor activity by subcellular localization. J. Cell Sci. 1993, 104, 949–955. [Google Scholar] [PubMed]
- Yang, K.; Liang, L.; Ran, F.; Liu, Y.; Li, Z.; Lan, H.; Gao, P.; Zhuang, Z.; Zhang, F.; Nie, X.; et al. The DmtA methyltransferase contributes to Aspergillus flavus conidiation, sclerotial production, aflatoxin biosynthesis and virulence. Sci. Rep. 2016, 6, 232–259. [Google Scholar] [CrossRef] [PubMed]
- Payne, G.A.; Brown, M.P. Genetics and Physiology of Aflatoxin Biosynthesis. Annu. Rev. Phytopathol. 1998, 36, 329–362. [Google Scholar] [CrossRef] [PubMed]
- Chang, P.K.; Scharfenstein, L.L.; Wei, Q.; Bhatnagar, D. Development and refinement of a high-efficiency gene-targeting system for Aspergillus flavus. J. Microbiol. Methods 2010, 81, 240–246. [Google Scholar] [CrossRef]
- Tamura, K.; Peterson, D.; Peterson, N.; Stecher, G.; Nei, M.; Kumar, S. MEGA5: molecular evolutionary genetics analysis using maximum likelihood, evolutionary distance, and maximum parsimony methods. Mol. Biol. Evol. 2011, 28, 2731–2739. [Google Scholar] [CrossRef]
- Yu, J.; Chang, P.K.; Ehrlich, K.C.; Cary, J.W.; Bhatnagar, D.; Cleveland, T.E.; Payne, G.A.; Linz, J.E.; Woloshuk, C.P.; Bennett, J.W. Clustered pathway genes in aflatoxin biosynthesis. Appl. Environ. Microbiol. 2004, 70, 1253–1262. [Google Scholar] [CrossRef]
- Bennett, J.W.; Papa, K.E. The Aflatoxigenic Aspergillus SPP. In Advances in Plant Pathology; Sidhu, G.S., Ed.; Academic Press: San Diego, CA, USA, 1988; pp. 263–280. [Google Scholar]
- Kale, S.P.; Cary, J.W.; Bhatnagar, D.; Bennett, J.W. Characterization of experimentally induced, nonaflatoxigenic variant strains of Aspergillus parasiticus. Appl. Environ. Microbiol. 1996, 62, 3399–3404. [Google Scholar]
- Georgianna, D.R.; Payne, G.A. Genetic regulation of aflatoxin biosynthesis: From gene to genome. Fungal Genet. Biol. 2009, 46, 113–125. [Google Scholar] [CrossRef] [PubMed]
- Chang, P.K.; Cary, J.W.; Bhatnagar, D.; Cleveland, T.E.; Bennett, J.W.; Linz, J.E.; Woloshuk, C.P.; Payne, G.A. Cloning of the Aspergillus parasiticus apa-2 gene associated with the regulation of aflatoxin biosynthesis. Appl. Environ. Microbiol. 1993, 59, 3273–3279. [Google Scholar] [PubMed]

| Strain | Characterization | Source |
|---|---|---|
| A. flavus SRRC1709 (CA14PTS) | ∆ku70, ∆pyrG, and ∆niaD, Used for gene deletion | [60] |
| WT | ∆ku70, ∆pyrG⸬AfpyrG, ∆niaD | This study |
| ∆areA | ∆ku70, ∆pyrG⸬AfpyrG, ∆niaD, ∆areA | This study |
| OE::areA | ∆ku70, ∆pyrG, ∆niaD, gpdA(p)⸬areA⸬AfpyrG | This study |
| Primer Name | Sequence 5′ to 3’ | Application |
|---|---|---|
| areA-F | ATTCGTAATACCTGCGTTCC | areA gene cloning |
| areA-R | GGGTGAAGAGCATTGTTTGAGGCCAGTCTACCCGCCCTAAA | |
| areA-AF | ATTCGTAATACCTGCGTTCC | 5′ UTR fragment amplification |
| areA-AR | GGGTGAAGAGCATTGTTTGAGGCCAGTCTACCCGCCCTAAA | |
| areA-BF | GCATCAGTGCCTCCTCTCAGACGAGGTGCAATGCGTTGGT | 3′ UTR fragment amplification |
| areA-BR | CTGGCCTGAAAGTGGGTG | |
| pyrG-F | GCCTCAAACAATGCTCTTCACCC | pyrG amplification |
| pyrG-R | GTCTGAGAGGAGGCACTGATGC | |
| areA-OF | CCCAGTTGCCCAACCAGGAG | areA ORF verification |
| areA-OR | GGTCGAGTAATTGGTGGCGTTC | |
| areA-NF | GTTTGACCGTCGCCTCAGTA | Fusion PCR |
| areA-NR | GGGTGGGTTGTTCGTGTTAG | |
| A-gpdA-F | CTTTCCCACTTCATCGCAGCTTGATGTCCGGGTTAACCCTCGG | areA ORF amplification for over-expression |
| A-gpdA-R | GGGCGTCCAAGGCATAATCG | |
| gpdA-F | GATCCCGTAATCAATTGCCCCATCCGGATGTCGAAGGCTT | gpdA(p) amplification |
| gpdA-R | GTGATGTCTGCTCAAGCGGGG | |
| P801-R | CAGGAGTTCTCGGGTTGTCG | AP fragment verification |
| P1020-F | ATCGGCAATACCGTCCAGAAGC | BP fragment verification |
| abaA-F | TCTTCGGTTGATGGATGATTTC | qRT-PCR qRT-PCR |
| abaA-R | CCGTTGGGAGGCTGGGT | |
| brlA-F | GCCTCCAGCGTCAACCTTC | qRT-PCR qRT-PCR |
| brlA-R | TCTCTTCAAATGCTCTTGCCTC | |
| sclR-F | CAATGAGCCTATGGGAGTGG | qRT-PCR qRT-PCR |
| sclR-R | ATCTTCGCCCGAGTGGTT | |
| nsdC-F | GCCAGACTTGCCAATCAC | qRT-PCR qRT-PCR |
| nsdC-R | CATCCACCTTGCCCTTTA | |
| nsdD-F | GGACTTGCGGGTCGTGCTA | qRT-PCR qRT-PCR |
| nsdD-R | AGAACGCTGGGTCTGGTGC | |
| areA-F | GAAACGGACGAGGCTAACAA | qRT-PCR qRT-PCR |
| areA-R | ATACTATGGTTCGCCGGATTG | |
| aflO-F | GATTGGGATGTGGTCATGCGATT | qRT-PCR |
| aflO-R | GCCTGGGTCCGAAGAATGC | |
| aflQ-F | GTCGCATATGCCCCGGTCGG | qRT-PCR |
| aflQ-R | GGCAACCAGTCGGGTTCCGG | |
| aflC-F | GTGGTGGTTGCCAATGCG | qRT-PCR |
| aflC-R | CTGAAACAGTAGGACGGGAGC | |
| aflD-F | GTGGTGGTTGCCAATGCG | qRT-PCR |
| aflD-R | CTGAAACAGTAGGACGGGAGC | |
| aflM-F | ATGTCCGACAACCACCGTTTAGATGGCA | qRT-PCR |
| aflM-R | CAATGATCTTTCCACTTACCCATTCGGCTG | |
| aflK-F | GAGCGACAGGAGTAACCGTAAG | qRT-PCR |
| aflK-R | CCGATTCCAGACACCATTAGCA | |
| aflP-F | ACGAAGCCACTGGTAGAGGAGATG | qRT-PCR |
| aflP-R | GTGAATGACGGCAGGCAGGT | |
| aflR-F | AAAGCACCCTGTCTTCCCTAAC | qRT-PCR |
| aflR-R | GAAGAGGTGGGTCAGTGTTTGTAG | |
| actin-F | ACGGTGTCGTCACAAACTGG | qRT-PCR qRT-PCR |
| actin-R | CGGTTGGACTTAGGGTTGATAG |
© 2019 by the authors. Licensee MDPI, Basel, Switzerland. This article is an open access article distributed under the terms and conditions of the Creative Commons Attribution (CC BY) license (http://creativecommons.org/licenses/by/4.0/).
Share and Cite
Fasoyin, O.E.; Yang, K.; Qiu, M.; Wang, B.; Wang, S.; Wang, S. Regulation of Morphology, Aflatoxin Production, and Virulence of Aspergillus flavus by the Major Nitrogen Regulatory Gene areA. Toxins 2019, 11, 718. https://doi.org/10.3390/toxins11120718
Fasoyin OE, Yang K, Qiu M, Wang B, Wang S, Wang S. Regulation of Morphology, Aflatoxin Production, and Virulence of Aspergillus flavus by the Major Nitrogen Regulatory Gene areA. Toxins. 2019; 11(12):718. https://doi.org/10.3390/toxins11120718
Chicago/Turabian StyleFasoyin, Opemipo Esther, Kunlong Yang, Mengguang Qiu, Bin Wang, Sen Wang, and Shihua Wang. 2019. "Regulation of Morphology, Aflatoxin Production, and Virulence of Aspergillus flavus by the Major Nitrogen Regulatory Gene areA" Toxins 11, no. 12: 718. https://doi.org/10.3390/toxins11120718
APA StyleFasoyin, O. E., Yang, K., Qiu, M., Wang, B., Wang, S., & Wang, S. (2019). Regulation of Morphology, Aflatoxin Production, and Virulence of Aspergillus flavus by the Major Nitrogen Regulatory Gene areA. Toxins, 11(12), 718. https://doi.org/10.3390/toxins11120718
